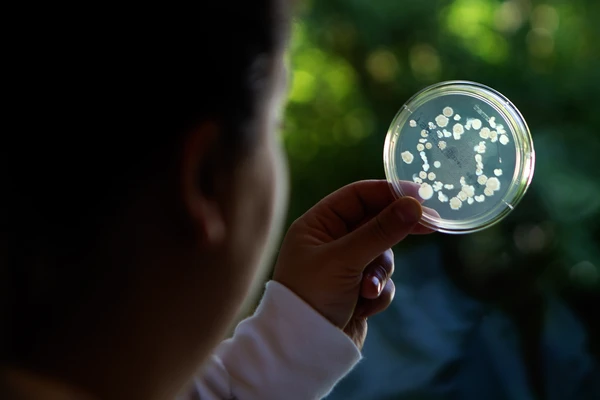
petri dish science

Poultry biosolutions
Better birds start with better biology
Our enzyme and probiotic biosolutions support poultry producers aiming for consistent performance, efficient production and healthy flocks. Trusted for broilers, layers, breeders and turkeys across systems worldwide.
Margins are tight.
Pressure is high.
Feed costs represent up to 75% of total live poultry production. Gut challenges threaten both performance and food safety. Feed efficiency and a robust gut microbiome are essential for consistent results. In today’s environment, small wins mean big gains for your bottom line.
Biosolutions for real-world poultry production
Our enzymes and probiotics support normal feed utilization and digestive health—working with your feeding and health strategy to help your birds reach their potential while supporting welfare, consistency and a more resilient production system.
Backed by science and a legacy of Chr. Hansen and Novozymes, Novonesis brings biosolutions, services, tools and partnership to help you produce smarter, unlocking your potential for profit.

A biosolution for all types of feed
Our enzymes let you get more from your feed.
Not only do they improve performance and help you cut costs – they also improve the health and nutrition of your animals.
From silage to swine, poultry to aquaculture – we have a biosolution for you.
Want to explore our range of poultry products?
Expertise that drives success
With deep expertise in silage making, we help producers and partners move their business forward. Our modern manufacturing with a global footprint, helps us deliver consistent, high-quality biosolutions—built to support your goals, batch after batch.
microbial excellence
dedicated to biosolutions for you
of all poultry feed uses our enzymes
Precision biosolutions for modern poultry
From hatch to harvest, our enzymes and probiotics support poultry where it matters most—on the feed and in the gut. With a flexible portfolio to fit your goals, we help you optimize feed use, support welfare and manage production risks. And we do it with precision and care that goes beyond standard.

Only effective and specialised enzymes

- Enzyme class: Protease
- ProAct 360™ thus further improves performance over RONOZYME® ProAct.
- Higher amino acid digestibility improvement for all amino acids
- Faster protein hydrolysis compared to RONOZYME ProAct.
- Works on a broad range of raw materials that allows flexible feed formulation.
- Better at degrading Anti-Nutrional Factors (ANF) like Trypsin inhibitors

- Enzyme class: Phytase
- HiPhorius™ raises the market standard for phytase technology, delivering world class efficient phosphorous utilization.
- HiPhorius™ is increasing the Phosphorus Digestibility, meaning that the use of expensive inorganic phosphates can be reduced significantly.
- HiPhorius™ contributes to reduction antinutritional effects of Phytate in the diets.
- HiPhorius™ recovery throughout the complete feed manufacturing process is excellent
- HiPhorius™ is a complete phytase solution for poultry, swine and aquaculture.

- Enzyme - Muramidase
- Through its unique mode of action, this patented technology helps optimize nutritional absorption and digestion, so animals get more from their feed.
- Balancius® breakthrough feed technology hydrolyzes peptidoglycans from bacterial cell debris in the intestinal tract.
Only effective probiotics for your flock

- Helps increase nutrients’ bioavailability via enzymatic mode of action
- Supports your operational profitability through cost savings
- Flexibility in application

- Reliable, predictable outcomes demonstrated in commercial trials
- Microbiome robustness
- Supports a healthy immune response
- Performance and nutritional efficiency with strong positive returns

- Reliable and proven product
- Supports digestive health and animal welfare
- Helps increase energy and protein availability
- Flexible use in application
Services and tools to delight you
Alongside our poultry biosolutions portfolio, we offer hands-on support and tools—from training to application support and various analyses. Ask your local Novonesis representative what’s available in your area to take your poultry business to the next level.
Contact our technical
experts today
Whether you're troubleshooting a challenge or exploring new feed strategies, our poultry experts are here to help. With deep industry knowledge and practical, science-backed support and services, we’ll help you find the right fit for your operation.
One more step…
To complete the get in touch form or sign up, please click on the button below to enable cookies.
Food for thought
Explore our articles and valuable educational content
How biosolutions work
Curious how probiotics and enzymes actually work? Discover how these biological tools support gut function, nutrient access and animal resilience.

Strains matter
Not all probiotics are created equal. The right strain makes all the difference when it comes to stability, activity, and results. Learn why strain selection is key to developing effective probiotic biosolutions for animal health and nutrition.

The power of a robust microbiome
Microbiome robustness is the ability of the intestinal microbiome to adapt to changing conditions while maintaining microbial balance and function. Explore how microbiome robustness benefits the animals in your care.